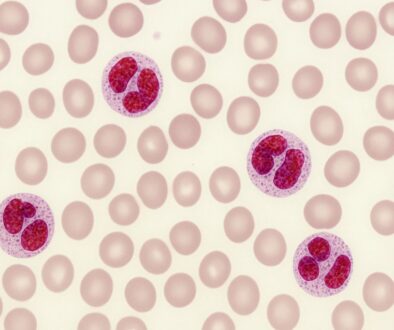

WIOSNA, ALERGIA I KORONAWIRUS – czyli jak przeżyć kolejny sezon pylenia w czasach pandemii
Autor:
Dr n. med. Magdalena Arcimowicz
Specjalista otolaryngolog – alergolog
Pandemia koronawirusa rozwinęła się dokładnie wraz z początkiem ubiegłorocznego sezonu pylenia. Przed nami kolejny sezon, i kolejna fala epidemii. Nie wiemy, jak będzie się kształtować krzywa zachorowań na COVID-19. Natomiast z dość dużym prawdopodobieństwem możemy przewidzieć, kiedy poszczególne alergeny kwitnących roślin pojawią się w powietrzu. W marcu będą pylić wczesne drzewa (olcha, leszczyna), w kwietniu brzoza, a potem późne drzewa (np. dąb). W maju rozpocznie się sezon pylenia traw, który swój szczyt osiągnie prawdopodobnie w czerwcu. Latem pojawią się w powietrzu atmosferycznym pyłki chwastów (np. bylicy), a od późnej wiosny do jesieni będą nam towarzyszyć zarodniki grzybów pleśniowych (Alternaria i Cladosporium). Dla pacjentów z pyłkowicą, czyli alergią sezonową, w przebiegu czulenia na pyłki, będzie to trudny czas.
Jak odróżnić COVID-19 od innych infekcji dróg oddechowych
Przeziębienie (ostra infekcja wirusowa górnych dróg oddechowych), różni się od COVID-19 przede wszystkim krótszym okresem inkubacji, obecnością kataru i zatkanym nosem (choć katar czasem występuje także przy infekcji koronawirusem), zdecydowanie częściej stanem podgorączkowym niż gorączką, obecnością bólu gardła, a rzadko nasilonym, duszącym kaszlem.
Natomiast grypa rozwija się z reguły dość gwałtownie, podczas gdy objawy COVID-19 nasilają się stopniowo (były przypadki, w których pacjent przechodził chorobę łagodnie i dopiero w drugim tygodniu objawy się zaostrzały i następowało pogorszenie).
Zakażenie nowym koronawirusem SARS-CoV-2 – w odróżnieniu od przeziębienia i grypy – dużo częściej objawia się także nasilającymi się kłopotami z oddychaniem.
COVID-19 a choroby alergiczne i astma
Obecnie nie można stwierdzić czy chorzy na alergiczny nieżyt nosa (ANN) mają większe prawdopodobieństwo infekcji koronawirusem SARS-COV-2 w porównaniu z populacją ogólną. Prawdopodobieństwo infekcji wśród pacjentów z ANN może być jednak większe w przypadku nieoptymalnego leczenia lub też zaniechania leczenia, co może prowadzić do nasilenia świądu oczu i nosa, kichania i wycieku z nosa. Wszystkie te objawy zmuszają pacjentów do zdecydowanie częstszego kontaktu rąk z oczami i nosem, a wtedy ryzyko wniknięcia wirusa się zwiększa. Uważa się również, iż w przypadku nieleczonego ANN, zmieniona zapalnie błona śluzowa nosa, przestaje pełnić funkcje bariery ochronnej i stanowi podatne wrota, wnikanie wirusa ta drogą jest znacznie łatwiejsze, i niesie ze sobą wyższe ryzyko zakażenia.
| COVID-19 | Przeziębienie | Grypa | Alergie sezonowe |
|---|---|---|---|---|
Okres inkubacji | 1-14 dni | 1-3 dni | 1-7 dni | Nie dotyczy |
Dynamika/przebieg | objawy od lekkich po ciężkie | powolny rozwój objawów | nagły rozwój objawów | z reguły nagły rozwój objawów |
Czas trwania | 7-25 dni | poniżej 14 dni | 7-14 dni | kilka tygodni, miesięcy nawroty, zaostrzenia (zależne od aktualnego pylenia, ekspozycji na alergeny) |
Kaszel | częsty (suchy) | częsty (łagodny) | częsty (suchy) | dość rzadki (przy współwystęowaniu astmy – częsty, suchy) |
Duszności, trudności w oddychaniu | Czasami | nie | nie | nie (jeśli astma – tak) |
Kichanie | nie | często | nie | czesto |
Wodnisty katar, blokada nosa | rzadko | często | czasami | bardzo często |
Ból gardła | czasami | często | czasami | Rzadko, (raczej podrażnienie) |
Świąd nosa (gardła) | nie | czasami | Nie | często |
Zapalenie spojówek | rzadko | czasami | Nie | często |
Zaburzenia węchu | czasami | dość często | nie | czasami |
Gorączka | często | czasami, krótko; częściej stan podgorączkowy | często | nie |
Dreszcze | często | nie | czasami | nie |
Zmęczenie | czasami | czasami | często | czasami |
Bóle głowy | czasami | rzadko |
| czasami (objawy „zatokowe”) |
Bóle mięśni | czasami | często | często | nie |
Biegunka | czasami | nie | czasami (dzieci) | nie |
Tabela 1: Diagnostyka różnicowa infekcji SARS-CoV-2, przeziębienia i grypy oraz chorób alergicznych (ANN – alergiczny nieżyt nosa).
Profesor Marek Jutel, Prezydent Europejskiej Akademii Alergologii i Immunologii Klinicznej, zwraca uwagę, że mechanizmy, które działają w przypadku alergii i infekcji COVID-19, są do siebie zbliżone i mogą się wzajemnie potęgować (eozynofile w ciężkim COVID przemieszczają się z krwi obwodowej do płuc, które uszkadzają; podobnie w astmie oskrzelowej niekontrolowanej/nieleczonej eozynofile uszkadzają oskrzela, predysponując do rozwoju choroby płuc spowodowanej zakażeniem koronawirusem). Ekspert podkreśla tym samym bardzo wyraźnie, że właściwe leczenie przeciwastmatyczne i przeciwalergiczne zmniejsza takie ryzyko zakażenia i zwiększa szanse na łagodne przechorowanie infekcji koronawirusowej.
Polskie Towarzystwo Alergologiczne i Polskie Towarzystwo Chorób Płuc, stoi na stanowisku, że w przypadku astmy, pacjenci, którzy przyjmują systematycznie leki wziewne, chorują tak samo jak osoby bez chorób współtowarzyszących. Podawanie sterydów wziewnych chroni ich przed cięższym przebiegiem COVID-19. Stanowisko to jest niezwykle ważne w kontekście nieprawdziwych informacji płynących z różnych pseudo-medycznych źródeł, które podają, że ponieważ sterydy obniżają odporność, nie należy ich brać, bo zwiększa to ryzyko ciężkiego przebiegu COVID-19. Warto raz jeszcze wyraźnie powtórzyć, że prawidłowe leczenie astmy oskrzelowej i alergicznego nieżytu nosa, nie tylko chroni pacjentów przed ryzykiem cięższego przebiegu COVID-19, ale być może także przed ryzykiem zakażenia koronawirusem.
Jak rozpoznać alergiczny nieżyt nosa (ANN)
O ile podstawowe różnice między infekcjami i ANN przedstawione zostały w tabeli 1, to istnieje szereg objawów, które są niezwykle typowe dla ANN i pozwalają z dużym prawdopodobieństwem na rozpoznanie tego schorzenia (tabela 2).
Różnicowanie | Objawy sugerujące ANN | Objawy z reguły niezwiązane z ANN |
|---|---|---|
Objawy | 2 lub więcej następujących objawów, trwających przez ≥ 1 godz. dziennie przez większość dni • wodnista wydzielina z nosa (±katar zanosowy, ściekanie wydzieliny po tylnej ścianie gardła) • kichanie, często salwami • blokada nosa • świąd nosa OBJAWY OBUSTRONNE !!! oraz ± zapalenie spojówek ± sezonowość objawów | każde objawy ze strony nosa jednostronne • izolowana blokada nosa • śluzowo-ropna wydzielina nosowa • nasilone ściekanie wydzieliny po tylnej ścianie gardła (post nasal drip), często gęstej z/bez typowego kataru • nawracające krwawienia/podkrwawiania z nosa • dolegliwości bólowe • brak węchu
|
Postępowanie | 1. sklasyfikuj i oceń nasilenie objawów – jeśli nasilone 2. sięgnij po leczenie OTC (leki bez recepty na alergię) 3. leczenie nieskuteczne – udaj się do lekarza, najlepiej alergologa |
PILNIE UDAJ SIĘ DO LEKARZA – konieczna konsultacja laryngologa |
Tabela 2: Jak rozpoznać ANN
W sezonowym ANN, u ponad 70% pacjentów mogą pojawiać się stale lub okresowo objawy alergicznego zapalenia spojówek. Również w tym przypadku farmaceuta może rozpoznać zapalenie spojówek i zaproponować racjonalne postępowanie (tabela 3).
Różnicowanie | Objawy sugerujące alergiczne zapalenie spojówek | Objawy niezwiązane z alerg. zap. spojówek |
|---|---|---|
Objawy | 1 lub więcej następujących objawów, trwających przez ≥ 1 godz. dziennie przez większość dni • towarzyszące objawy nieżytu nosa(tab. 2) • OBUSTRONNE OBJAWY OCZNE !!! • świąd oczu • łzawienie • zaczerwienienie oczu • brak fotofobii (nadwrażliwości na światło) ± sezonowość objawów
b. rzadko pogorszenie widzenia | 1 lub więcej następujących objawów • brak związku z nieżytem nosa • każde objawy oczne jednostronne • brak świądu • pieczenie oczu • suchość oczu • fotofobia (nadwrażliwość na światło) • pogorszenie widzenia
|
Postępowanie | sklasyfikuj i oceń nasilenie objawów – objawu bardzo nasilone, ew. z pogorszeniem widzenia – pilnie udaj się do lekarza (alergologa, okulisty) – objawy łagodne, umiarkowane – sięgnij po leczenie OTC – leki bez recepty (brak skuteczności leczenia po kilku dniach – udaj się do lekarza) |
PILNIE UDAJ SIĘ DO LEKARZA OKULISTY |
Tabela 2: Jak rozpoznać alergiczne zapalenie spojówek
Uwaga: zdecydowana większość alergicznych zapaleń spojówek przebiega bez zaburzeń ostrości widzenia, jeśli pacjent zgłasza pogorszenie wzroku, konieczna jest pilna konsultacja okulisty.
Leki OTC (dostępne bez recepty) i możliwości leczenia sezonowego alergicznego nieżytu nosa (pyłkowicy) – czyli jak sobie pomóc, zanim trafi się do lekarza.
Kategoria OTC w leczeniu chorób alergicznych, od kilku lat dotyczy większości leków przeciwhistaminowych, zarówno doustnych, jak i miejscowych, a od stosunkowo niedawna również glikokortykosteroidów donosowych, np. mometazonu.
Objawy
Grupa leków | Kichanie | Wodnista wydzielina | Świąd nosa | Blokada nosa | Objawy oczne |
|---|---|---|---|---|---|
sterydy donosowe | ++ | ++ | ++ | +++ | ++ |
p/histaminowedoustne | ++ | ++ | +++ | +/- | ++ |
p/histaminowedonosowe | ++ | ++ | ++ | + | 0 |
p/histaminowe do oczu | 0 | 0 | 0 | 0 | +++ |
Kromony donosowe | + | + | + | +/- | 0 |
Kromony do oczu | 0 | 0 | 0 | 0 | + |
Leki obkurczające donosowe | 0 | 0 | 0 | ++++ | 0 |
Leki obkurczające doustne (pseudoefedryna | 0 | 0 | 0 | ++ | 0 |
Tabela 3: Leki OTC w leczeniu ANN, wpływ na objawy
Zawsze zapytaj farmaceuty o możliwości leczenia i odpowiedni dobór leku.
Jeśli objawy nie ustępują, lub ulegają pogorszeniu, pojawiają się duszności – koniecznie udaj się do Lekarza Rodzinnego lub specjalisty alergologa.
Śledź na bieżąco stężenia alergenów.
Prowadź dzienniczek objawów.
(Wykorzystaj aplikacje mobilne)Przed kolejnym sezonem, najlepiej już na jesieni, rozważ diagnostykę alergologiczną (testy skórne i/lub badania z krwi) i omów z lekarzem alergologiem możliwości przyczynowego leczenia alergii, czyli odczulania, zwanego immunoterapią alergenową.